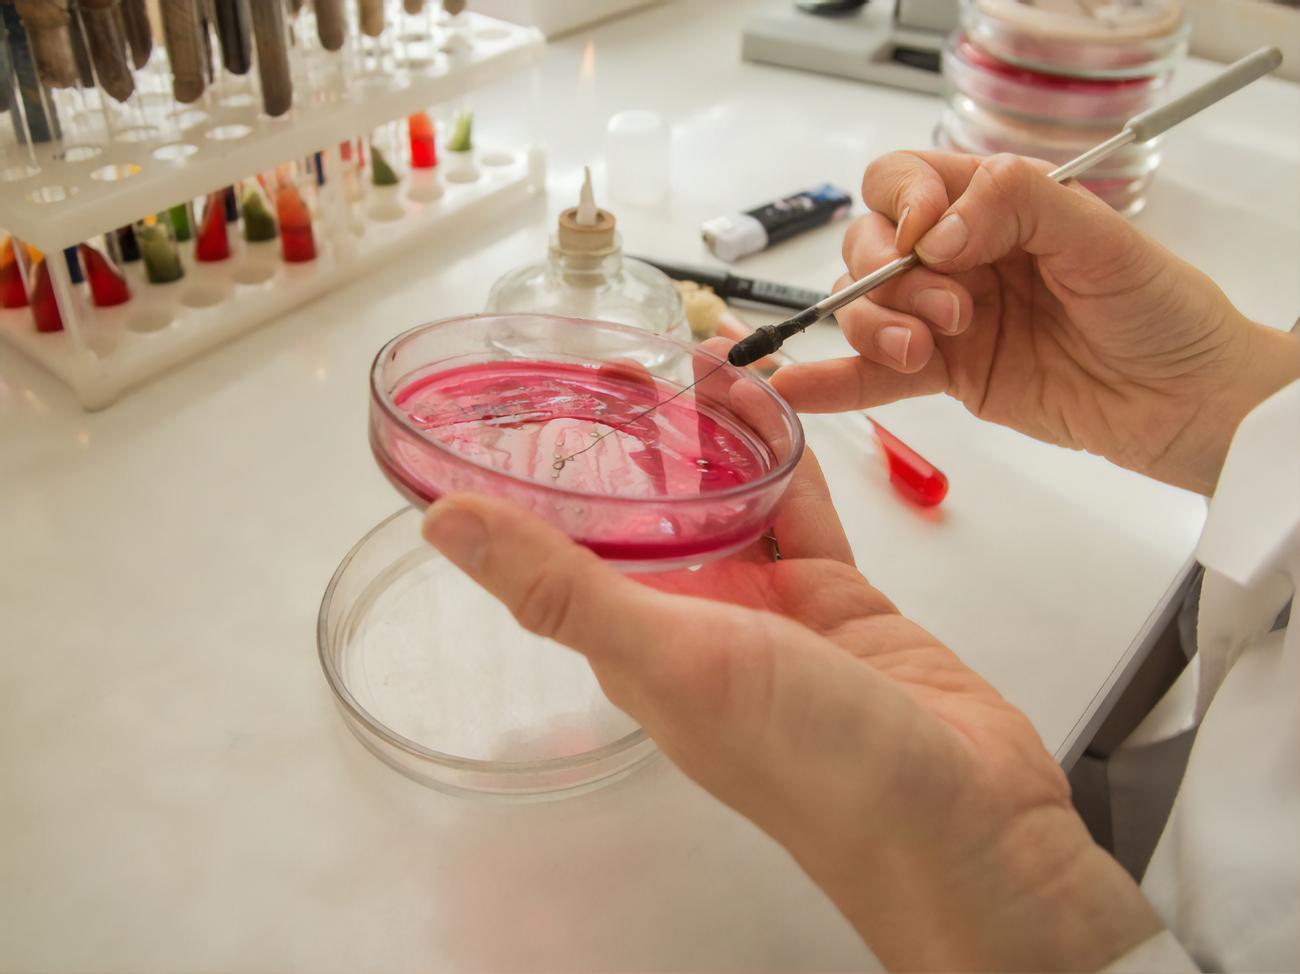

Посев л
Голосящий кивин 2012
Цикл 35 когда овуляции
Musk empire эпизод 51 видео
Зейнеп бонче сценарист
Симуляторы farming simulator 22
Когда пенсионеры получат проиндексированную пенсию
Альдо бруе обувь
Циферблат для хуавей вотч
Читать форум forum
Привет из лета любимой
Аксамон таблетки для чего назначают взрослым отзывы
Витязево комнаты посуточно
Какой должен прогревочные обороты
Посев л 133 фотографий